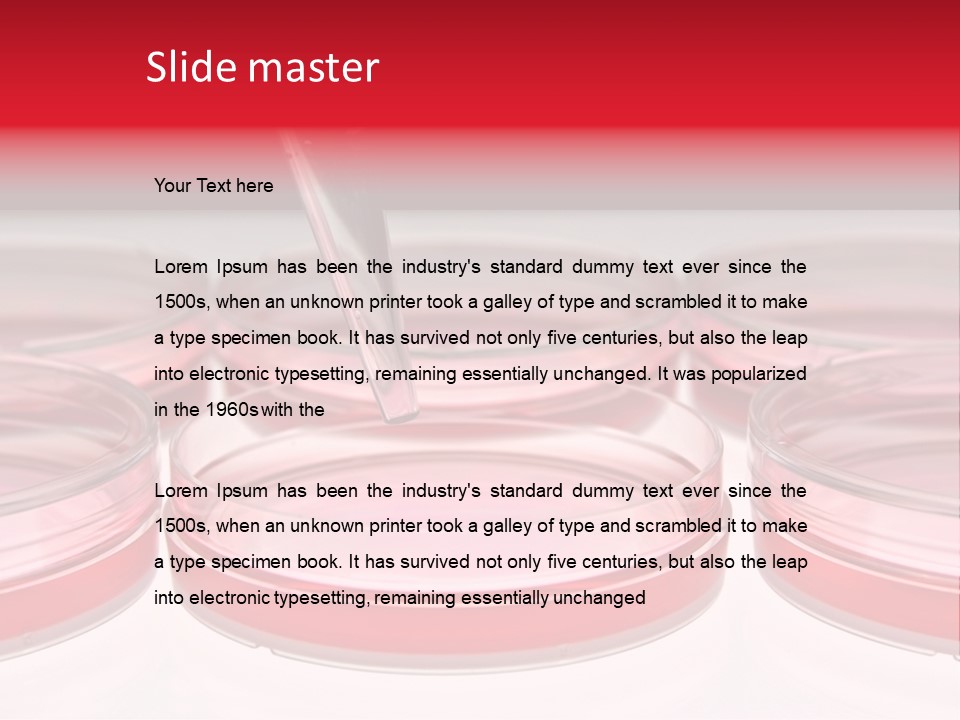
Research Petri Biotechnology PowerPoint Template
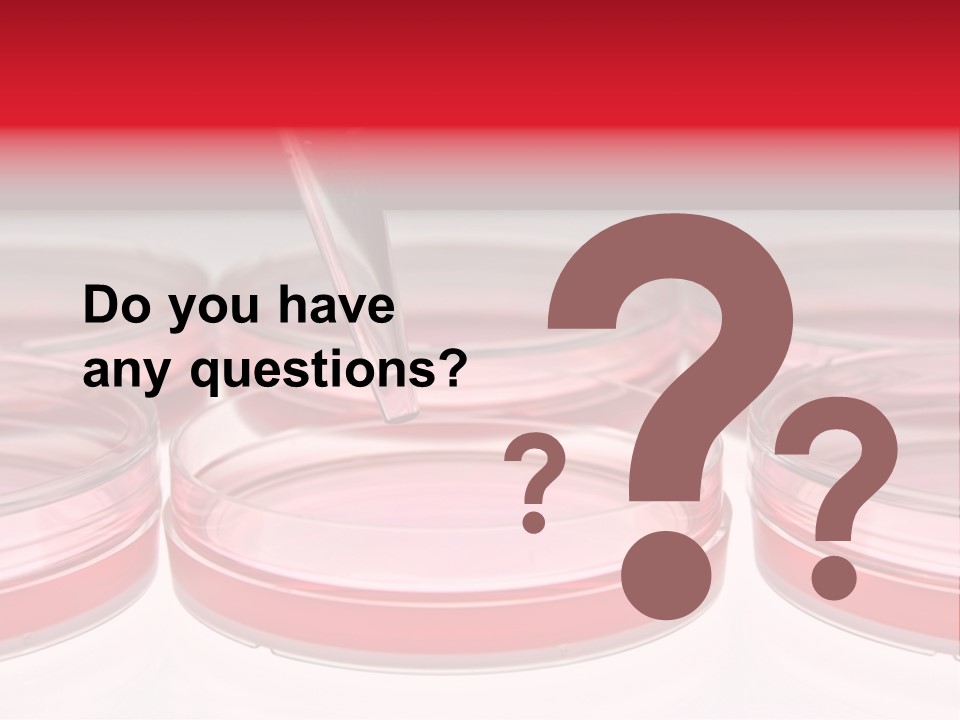
Research Petri Biotechnology PowerPoint Template

Research Petri Biotechnology PowerPoint Template
ID: PPT-0000126717
Standard Stock-Templates License
Free for personal and commercial use with attribution required.
Free
3 slides
Free
90 slides
-
Slides:
3 or 90 Slides
-
Compatible with:
Microsoft PowerPoint, Google Slides, Apache OpenOffice, Apple Keynote
-
Aspect Ratio:
1024x768
4:3 @ 96 dpi (Normal),
16:9 (Widescreen) -
File Type:
PPT, PPTX
-
File Size:
1023.12 KB - 1.32 MB
-
Download File Type:
ZIP
-
Created:
August 17, 2016
liquid
eye
solution
fluid
cosmetics
medical equipment
perfume
paint
beaker
eyelash
laboratory equipment
magenta
tints and shades
personal care
service
solvent
glass
science
transparent material
fashion accessory
automotive lighting
event
peach
electric blue
drinkware
transparency
barware
circle
laboratory flask
plastic
still life photography
font
skin care
metal
gloss